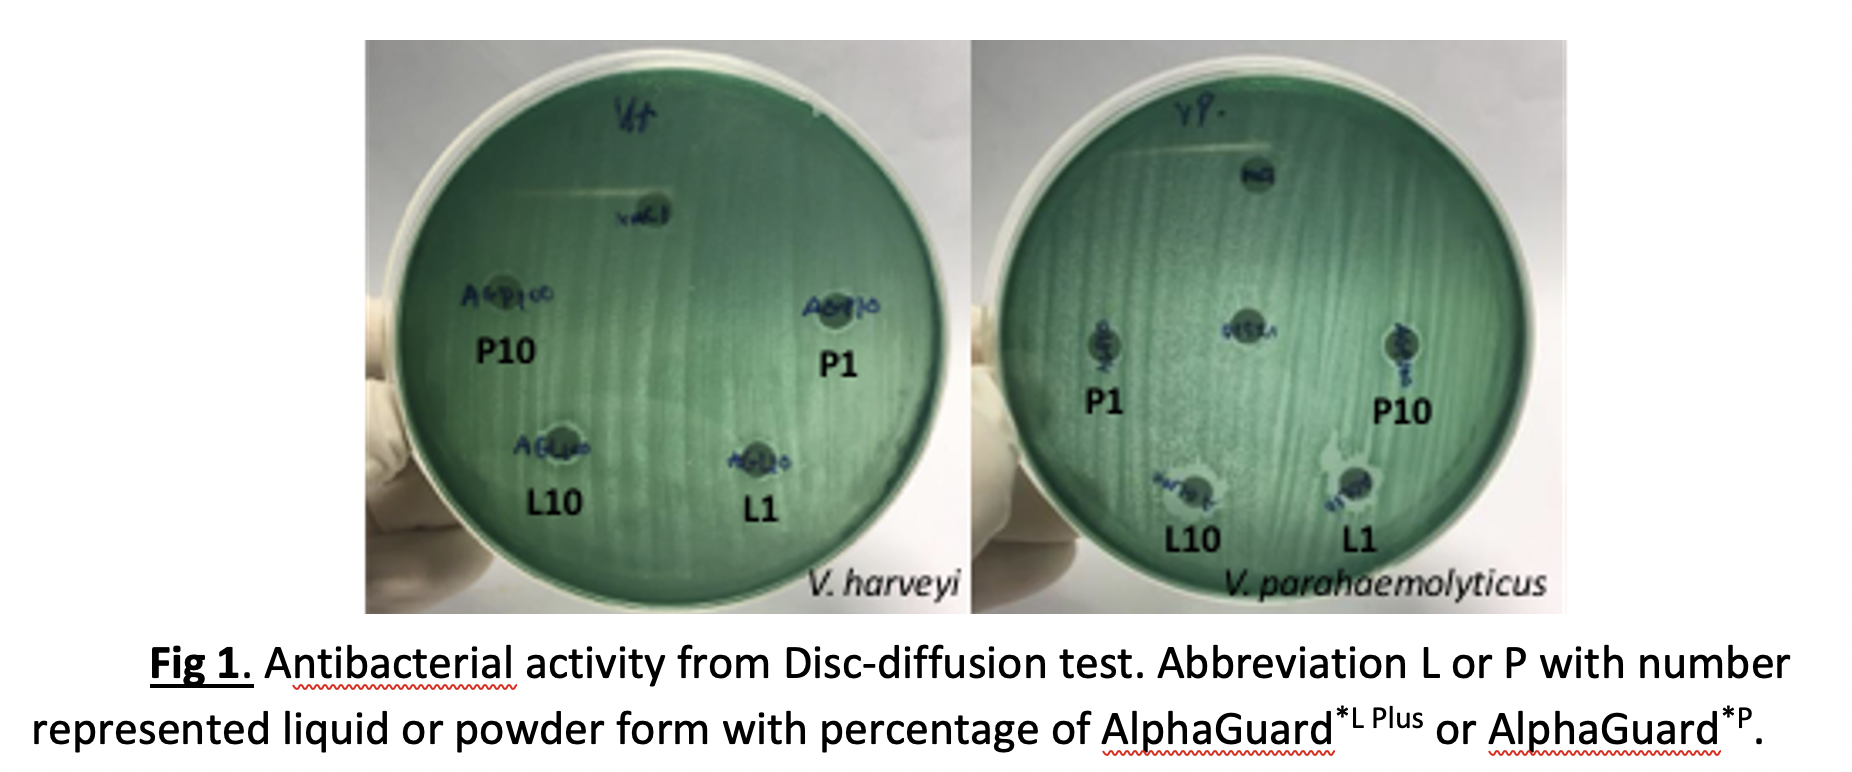

Shrimp aquaculture has been dramatically affected by many pathogenic diseases, mainly caused by V. parahaemolyticus and White Spot Syndrome Virus (WSSV). The aim of this study was to evaluate the potential use of 2 functional feed additives of AlphaGuard*L Plus (Liquid) and AlphaGuard*P (Powder) composed of Essential Oils (Eucalyptus, Thyme, Oregano belonging to Myrtaceae and Lamiaceae family respectively), Medium Chain Triglycerides (MCTs) and natural bioactive compound in shrimp against disease caused pathogens especially V. parahaemolyticus and WSSV. No significant differences in growth performance were found at 0.5% of AlphaGuard*P and AlphaGuard*L PLUS. The results indicated that AlphaGuard*L Plus effectively delayed disease progress in shrimp. These results suggest that the functional feed additive of AlphaGuard*P and AlphaGuard*L PLUS could be used in order to promote shrimp’s defense against pathogens.
Keywords: Functional Feed Additive, AlphaGuard, Litopenaeus vannamei, Vibrio, White spot disease
The practice of aquaculture intensification is impeded by health and nutrition - affecting growth performance. To untangle these consequences, functional feed additives have been used to stimulate shrimp immune and improve shrimp performance specially to control viral and bacterial pathogens in recent treat shrimp diseases (Thimadee et al., 2016) such as V. parahaemolyticus that caused Acute Hepatopancreatic Necrosis Disease (AHPND) and White spot syndrome virus (WSSV) that caused White spot disease (WSD) combined with the implementation of biosecurity measures. The composition of AlphaGuard composing MCT and essential oil are being recognized as GRAS practice. In this study, the efficiency of AlphaGuard product was obtained by a combination of the data from Disc-diffusion test result, disease challenge, histology and growth performance together with an evaluation of AlphaGuard product effect on the shrimp diseases.
Two virulent pathogens in shrimp, V. parahaemolyticus and V. harveyi in glycerol stock, have been sub-cultured in Tryptic Soy Broth (TSB) + 1% NaCl, incubated at 37oC for 24 hours before streaked onto Thiosulfate-citrate-bile salts-sucrose agar to obtain its pure culture. WSSV suspension was prepared from the muscle of WSSV infected shrimp. Briefly, the WSSV-containing in shrimp the muscle was removed from storage at -80°C and cut into uniform pieces under cold sterile conditions then homogenized in TN buffer (20 mM Tris-HCl, 400 mM NaCl, pH 7.4) at 0.1 g/ ml. After centrifugation at 2,000 rpm for 10 min at 4°C, the supernatant was diluted to 1:100 with 0.9% NaCl and filtered through 0.45 micron. The resulting supernatant was stored at -80°C until used as a source of WSSV injection for the experiments.
The antimicrobial activity
-Disc-diffusion test5 µl of the of AlphaGuard*L Plus and AlphaGuard*P, concentration ranging from 0, 0.25, 0.5, 1.0, 10% dilution with NaCl 0.85%, were absorbed into 5 mm diameter, 0.9 mm thick paper disc then air drying before placed to 105 cells of bacteria culture in a Petri dish size 100 x 15 mm. 0.85% NaCl solution was used as negative control. Three replicate plates for each treatment were used. Observations were recorded after 24 hours.
V. parahaemolyticus was reactivated from storage at -80°C and cultured in TSB + 1% NaCl at 37°C overnight. The culture was centrifuged at 5,000 rpm for 10 min to remove the supernatant, and the pellet was re-suspended in sterile 0.85% NaCl to a density of 8.4×106 CFU/ml. The shrimps at 5th week were infected by injecting 100 μL of the bacterial suspension into the second abdominal segment of healthy shrimp at 5th week of culture and mortality was recorded for 7 days. Shrimps were collected randomly at 3rd day after infection for each treatment and washed three times with sterile water. HL was withdrawn from the pericardial cavity using a 1-mL sterile disposable syringe under sterile conditions and added to an equal volume of sterile anticoagulant (adding 10 mM EDTA-Na2 to 450 mM NaCl, 10 mM KCl, 10 mM HEPES, pH 7.3, 850 mOsm.kg-1 or 10 mM Tris-HCl, 250 mM Sucrose, 100 mM Sodium citrate, pH 7.6). The HL and ground HP were serially diluted 10-fold with cold sterile PBS. Each dilution was spread on TCBS agar plates placed upside down in a 37°C incubator and cultured for 16–20 hours. Plates containing 30–300 bacterial colonies were counted, then the numbers were recorded as CFU/ml or CFU/g.
0.1 ml of the filtrate was injected intramuscularly into healthy shrimp at 5th week of culture. Shrimps were collected randomly at 6 hours after infection for Histopathology examination (Bell T.A. and Lightner D.V. 1988) and recorded mortality for 7 days.
Shrimps were purchased from local Thai farm. There were negative from V. parahaemolyticus caused AHNPD and WSSV by PCR analysis. After acclimatized for one week in aquarium prior the experiment, apparently healthy shrimp with uniform body length was divided randomly into 3 groups with 6 replicates per group, 20 shrimps per replicate. Aquarium capacity was 100 liters containing 60 liters of sea water. Saline water property was maintained at 15 ppt, pH 7.7-8.0 and DO>4.0 mg/L. Each treatment contains juvenile shrimps with an average initial weight of 2.6 g randomly stocked in each tank. Shrimps were fed to satiation around 2.5-3% of body weight, three times per day throughout 5 weeks. Feeding was adjusted daily according to ingested rate to make sure that feed was totally consumed. Before feeding, molts, feces, and dead shrimps were removed. 20% of the water in each tank was exchanged every 3 days by new seawater.
All groups were kept during the experiment under the same conditions as acclimation. Control group was fed by commercial shrimp pellet coated with 1% chitin-chitosan. Treatment groups were fed by AlphaGuard*L Plus or AlphaGuard*P sprayed on commercial shrimp pellet and coated by 1% chitin-chitosan at dosage 5.0 ml or g/Kg feed Feed intake, mortality and water quality parameters were recorded daily. At the end of the trial, the survival rate was evaluated. Shrimp weights were determined at the beginning (Initial Weight), third and fifth (Final Weight) week of the experiment. Weight gain and feed consumption were used to calculate several parameters; Feed conversion ratio (FCR) = feed consumed (dry weight)/live weight gain (wet weight). Daily Weight Gain (DWG; g/day) was calculated as: (Final weight (g) − Initial weight (g))/days.
Statistical analysis experimental units, tanks, and aquariums were distributed in a completely randomized way. Quantitative data were checked for normality and homoscedasticity. Data were analyzed using one-way analysis of variance (ANOVA) to search for significant (p < 0.05) differences among treatment means.
The antibacterial activity by Disc-diffusion method and inclusion in shrimp diet on disease resistance of AlphaGuard*L Plus or AlphaGuard*P
-Disc-diffusion test
The concentrations of AlphaGuard*L Plus and AlphaGuard*P at least 1% inhibit both V. harveyi and V. parahaemolyticus, however, there was higher inhibition efficacy for V. parahaemolyticus compare than V. harveyi. The effective concentration of AlphaGuard might be lowered if we diluted in lipid soluble such as Ethanol for testing. As the lipid compounds in AlphaGuard may not disperse appropriately across the culture medium. Essential oil compositions, assay techniques and the mode of action have been intensively reviewed (Chouhan et. al. 2017, Citarasu 2010, Faleiro 2011 Nieto 2017, Padalia et. al. 2015 and Zhang et. al. 2010). In this study did not investigate at molecular details for its mechanisms, however, the main effect of bacteriocidal properties might be related to their interference at membrane integrity and permeability as the lipophilic compound from essential oil and MCTs. Different fatty acids in MCTs have a different minimum inhibitory concentration (MIC), depending on the type of fatty acid, microorganism, and environmental pH. The synergistic and antagonistic aspect between ingredients in AlphaGuard is not elucidated in this study. The essential oil in AlphaGuard also acts as an antioxidant to prevent or slow down oxidation of unsaturated MCTs to prolong its shelf life besides anti-stress in shrimp.
-V. parahaemolyticus challenge test
-V. parahaemolyticus challenge testAt the end of feed trial experiment after 5th week, shrimps were challenged by V. parahaemolyticus. Cumulative mortality rate is plotted in graph as Fig. 2. The results of mortality rate after V. parahaemolyticus challenge for 7 days’ interval showed that groups of shrimp fed by AlphaGuard*P and AlphaGuard*L Plus had lower mortality rate significantly than control group after day 4th of infection. Both AlphaGuard*P and AlphaGuard*L Plus had the same statistical mortality rate after day 5th of infection. At the end of experiment as Fig. 3, in contrast, survival rate not statistically correlated to mortality rate for AlphaGuard*P.

The ability of shrimp clearance from Vibrio spp. after 3 days of infection was plotted graph as in Fig. 4. The results indicated that the Vibrio spp. count in hemolymph of shrimp fed by AlphaGuard*P and AlphaGuard*L Plus were lower than control significantly whereas the ability of shrimp to defense against bacteria in HP found that group of shrimp fed by AlphaGuard*L Plus had better ability significantly than shrimp fed by AlphaGuard*P and control.
WSSV challenge test was conducted after 5th weeks of the feeding trial. The cumulative mortality was plotted as graph in Fig. 5. The group of shrimp fed by AlphaGuard*L Plus is shown significantly delay in the mortality compare to the groups of control and AlphaGuard*P during 2nd to 4th day as shown in Fig.6. This is coincided with no histopathological sign of H&E staining WSSV infection tissue at the area of injection except the generalization of muscle necrosis that is likely related to the shrimp defense mechanism after 3 days of infection. Nevertheless, all groups ended up with 100% mortality. The group of AlphaGuard*P exhibited some sign of fungi infection by fibrous invading to sub-epithelial tissues in Fig 6 (3) and (4).

(1) Control and (2) AlphaGuard*P shown the late stage of intranuclear inclusion body of WSSV infection to HP as indicated by black arrow. (3) AlphaGuard*P exhibited some signs of fungi infection by fibrous invading to sub-epithelial tissues. (4) Zoomed-in area from black rectangle from black arrow indicated in (3). (5) and (6) AlphaGuard*L Plus shown no evidence of WSSV infection but it demonstrated the generalized muscle necrosis.
Alphaguard might have triggered or modulated a series of non-specific immune responses against shrimp pathogens, however this needs to be confirm via haemocyte count, pro-phenoloxidase activity or immune-related gene expression as the example indicators.
Effects of AlphaGuard*L Plus and AlphaGuard*P on L. vannamei growth performance
Growth performances of AlphaGuard*L Plus and AlphaGuard*P at 0.5% applications starting from 1st week until 3rd week were no significant differences for all parameters from control in Fig.7. Weight gain increased and FCR decreased than control but there was no statistical difference. MCTs can be modified the gastrointestinal morphology such as increased intestinal microvillus or crypt depth as found in piglet or fish, nevertheless, we need to confirm this by more research on section of hepatopancrease lumen in shrimp. AlphaGuard could also induce better resorption of liposoluble vitamins due to its lipophilic properties. The overall of the growth performance should be elucidated further in the real pond.

 Conclusion
Conclusion
The results of this trial suggested that the application of AlphaGuard*P and AlphaGuard*L Plus feed additive at 0.5% with commercial feed proved the efficacy on promoting the shrimp defense against pathogen. Especially with AlphaGuard*L Plus showing a better performance.
ACKNOWLEDGMENTSAll experiments were conducted at the Nutrition and Aquafeed Laboratory, Department of Aquaculture, Faculty of Fisheries, Kasetsart University, Bangkok, Thailand. Bacteria and virus were provided from the Department of Fisheries, Kasetsart University in Thailand.
CONFLICTS OF INTERESTThe authors declare no conflict of interest.
REFERENCESBell TA and Lightner DV. 1988. A Handbook of Normal Penaeid Shrimp Histology” The World Aquaculture Society. Chouhan S, Sharma K, Guleria S. 2017. Antimicrobial activity of some essential oils-Present status and future perpectives. Medicines 4, 58. Citarasu T. 2010. Herbal biomedicines: a new opportunity for aquaculture industry. Aquacult Int 18:403-414. Faleiro ML. 2011. The mode of antibacterial action of essential oils. Science against microbial pathogens: communicating current research and technological advances. Nieto G. 2017. Biological activities of three essential oils of the Lamiaceae family. Medicines 4, 63. Padalia H, Moteriya P, Baravalia Y, Chanda S. 2015. Antimicrobial and synergistic effects of some essential oils to fight against microbial pathogen. The battle against microbial pathogens: Basic science, Technological advances and educational programs. Thitamadee S, Prachumwat A, Srisala J, Jaroenlak P, Salajan PV, Sritunjalucksana K, Flegel TW. 2016. Review of current disease threats for cultivated penaeid shrimp in Asia. Aquaculture 452:69-87 Zhang J, An M, Wu H, Stanton R, Lemerle D. 2010. Chemistry and bioactivity of eucalyptus essential oils. Allelopathy Journal 25 (2): 313-330